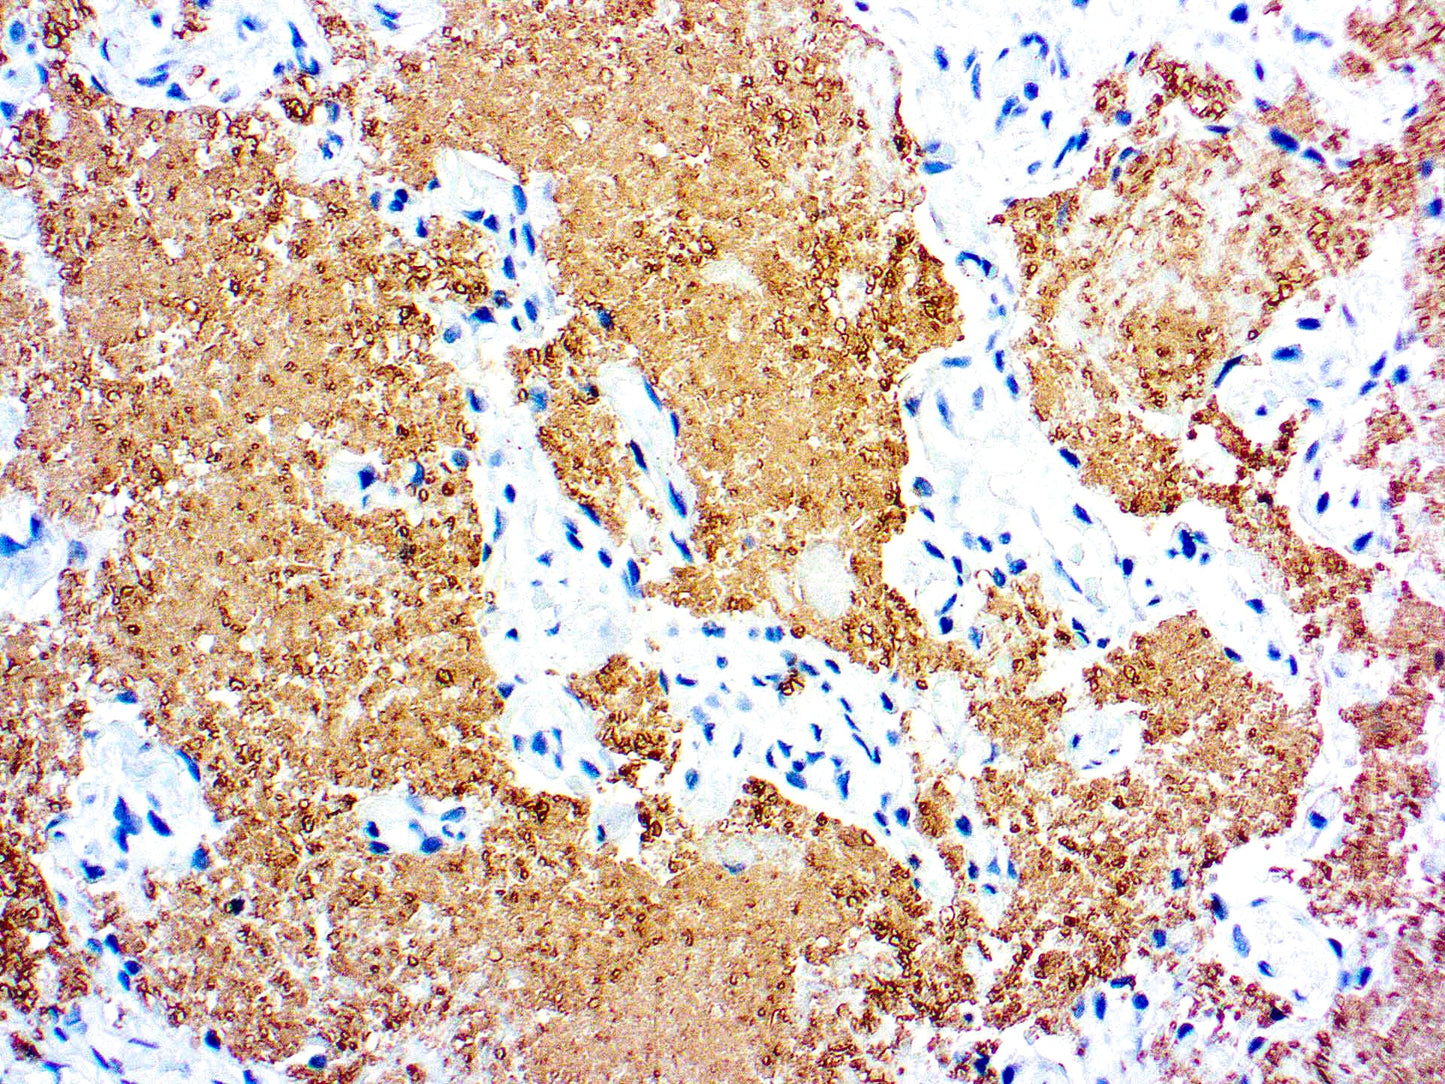
Pneumocystis carinii

1
/
of
1
Dbiosys
SKU:Mob091
Pneumocystis carinii
Pneumocystis carinii
Regular price
$712.00 USD
Regular price
Sale price
$712.00 USD
Unit price
/
per
Shipping calculated at checkout.
Couldn't load pickup availability
This antibody reacts with P. carinii in the fixed human tissues. The antibody is specific against an 82 kDa parasite specific polypeptide. It does not crossreact with G. lamblia, T. gondii, T. cruzi, L. tropica, E. histolytica, C. albicans and P. falciparum.
Share